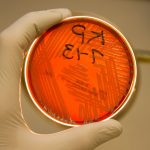

Set against the breathtaking backdrop of the Canadian Rockies, where sunlight spills over pristine waters and jagged landscapes, model Awar Odhiang and her family demonstrate the perfect blend of practicality and style.

AND WE’LL ALL FLOAT ON
Awar beams in a sky blue Prada jacket (prada.com) and Loewe waders and shoes (loewe.com).

THIS SIDE OF PARADISE
Awar’s family, originally from South Sudan, fled the civil war and settled in Calgary, close to these stunning locations. Pictured from left: Awar’s mother, Achalla Opiew; Awar’s younger sister, model Nepapery Odhiang; and Awar, dressed in a Victoria Beckham jacket and Duran Lantink skirt.

ALL TOGETHER NOW
Adventuring in stylish Sacai jackets and skirts, Awar and Nepapery pose playfully. Nepapery pairs her jacket with a striped Bode top, while Achalla stands out in a Loro Piana vest and a Michael Kors Collection dress.

GIANT STEPS
Awar confidently ventures forward in a Snow Goose by Canada Goose windbreaker and Le Chameau boots.